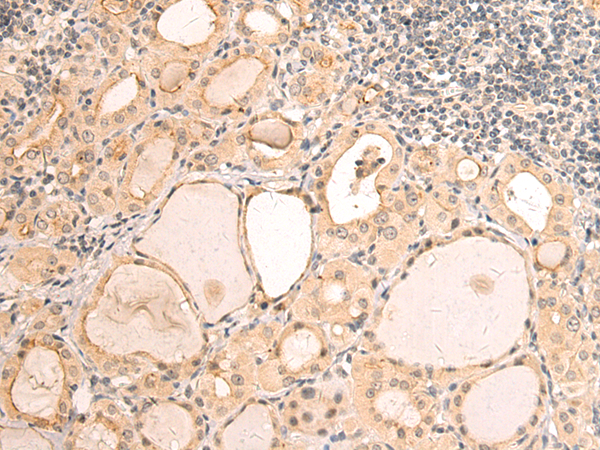
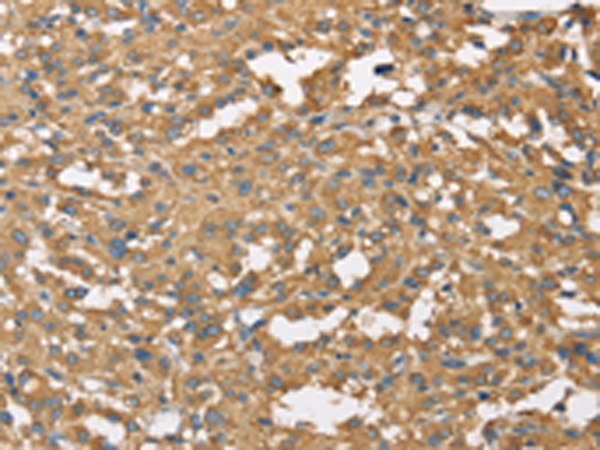
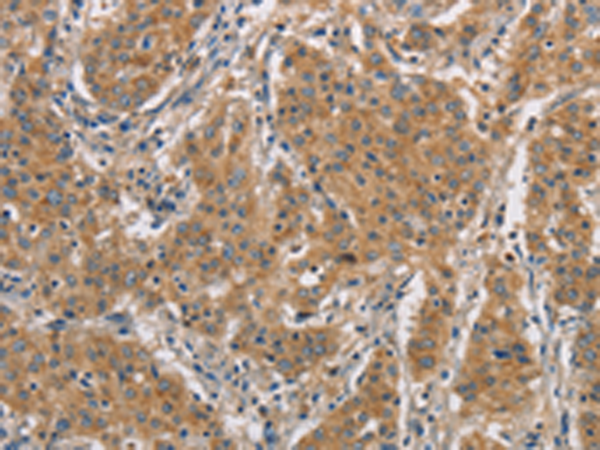

-
分类: 科研抗体货号: P08223别名: DCTN22; DCTN-22应用: IHC反应种属: Human
-
分类: 科研抗体货号: P08206别名: GIG1; CYR61; IGFBP10应用: WB,IHC反应种属: Human, Mouse, Rat
-
分类: 科研抗体货号: P08222别名: RBP50; DCTN50; HEL-S-77; DYNAMITIN应用: WB,IHC反应种属: Human, Mouse, Rat
-
分类: 科研抗体货号: P08204别名: TS; TXS; CYP5; THAS; TXAS; CYP5A1; GHOSAL; BDPLT14应用: IHC反应种属: Human
-
分类: 科研抗体货号: P08221别名: P135; DP-150; DAP-150应用: WB,IHC反应种属: Human, Mouse, Rat
-
分类: 科研抗体货号: P08203别名: RY; APG-2; HSPH2; hsp70; hsp70RY; HS24/P52应用: WB,IHC反应种属: Human, Mouse
-
分类: 科研抗体货号: P08219别名: SMIF; SMAD4IP1; HSA275986; Nbla00360应用: WB,IHC反应种属: Human, Mouse
-
分类: 科研抗体货号: P08201别名: CPT7; CYP17; S17AH; P450C17应用: IHC反应种属: Human
-
分类: 科研抗体货号: P08218别名: ESDN; CLCP1应用: IHC反应种属: Human, Mouse, Rat
-
分类: 科研抗体货号: P08200别名: CYP11A; CYPXIA1; P450SCC应用: IHC反应种属: Human

鄂公网安备42018502007531号
鄂公网安备42018502007531号

